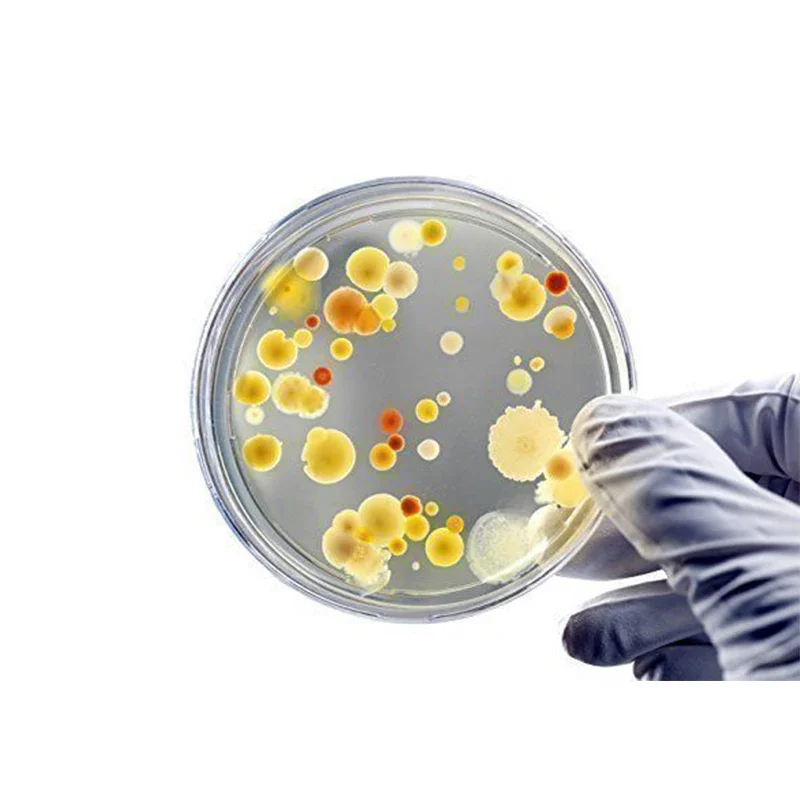
thumb

LED display Colony Counter for counting germs
Price history chart & currency exchange rate
Customers also viewed

$2.06
2Pcs E10 Led Flashlight Bulb DC 3V Instrument Bulb Indicator Lamp Replacement Torch Bulb Lamp Warm White/White Flashlight Bulbs
aliexpress.com
$6.96
Cutting Pliers Nipper Diagonal Plier Cutter Protective Case Storage Box DIY Hobby Military Model Handicraft Making Tools
aliexpress.com
$11.29
Абсорбирующее полотенце для лица из чистого хлопка с атласной отделкой Gold, 72x35 см, 100 г 72x35 красный
joom.ru
$5.09
Cup Cover Lid Mug Silicone Lids Coffee Covers Round Drink Replacement Proof Leakleakproof Drinkingseal Tea Hot Universal Can Cap
aliexpress.ru
$27.56
Женское Трикотажное изделие BER & OYS & ZA2022, с круглым вырезом, металлической линией и бриллиантами, осень/зима, 5802158
aliexpress.ru
$2.67
Color wound wire spiral in the cable bushing harness, motorcycle heat pipe protector cover tube winding tube 2M
aliexpress.com
$42.00
Sbart 3mm Neoprene Long Sleeves Men Wetsuit Jacket OpenCell Black Wet Suit for Snorkeling Surfing Scuba Diving Spearfishing Suit
aliexpress.com
$4.90
1Pcs Crystal Silicone Bear Heart Mold Geometry Stereo Bear Mould Mirror Silicone Mold for DIY Silicone Jewelry Making Tool
aliexpress.com
$17.86
Women Suede Boots 2021 Winter Warm Boots Platform Shoes Snow Botas De Mujer Waterproof Low Heels Ankle Boots Women Leather Shoes
aliexpress.com
$4.69
Women's Men's Anime Demon Slayer Bucket Hats Cosplay Fisherman Hat Summer Panama Outdoor Sunscreen Bucket Hat Bone Bonnets Bob
aliexpress.com
$2.51
Japan anime cells at work Phone Case For Samsung galaxy A S note 10 7 8 9 20 30 31 40 50 51 70 71 21 s ultra plus
aliexpress.com
$38.78
Kids Cotton Swing Hammock for Autism ADHD ADD Therapy Cuddle Up Sensory Child Therapy Elastic Parcel Steady Seat Swing chairtoy
aliexpress.com
$98.80
646908-003 For HP Omni 120 AIO motherboard DA0WJ5MB6E0 665465-001 motherboard 100%tested fully work
aliexpress.com
$44.82
Lixada Digital Fishing Alarm Wireless Bite Alarms Set Fishing Receiver Sound Alert Kit Led Alarm Indicator with Portable Case
aliexpress.com